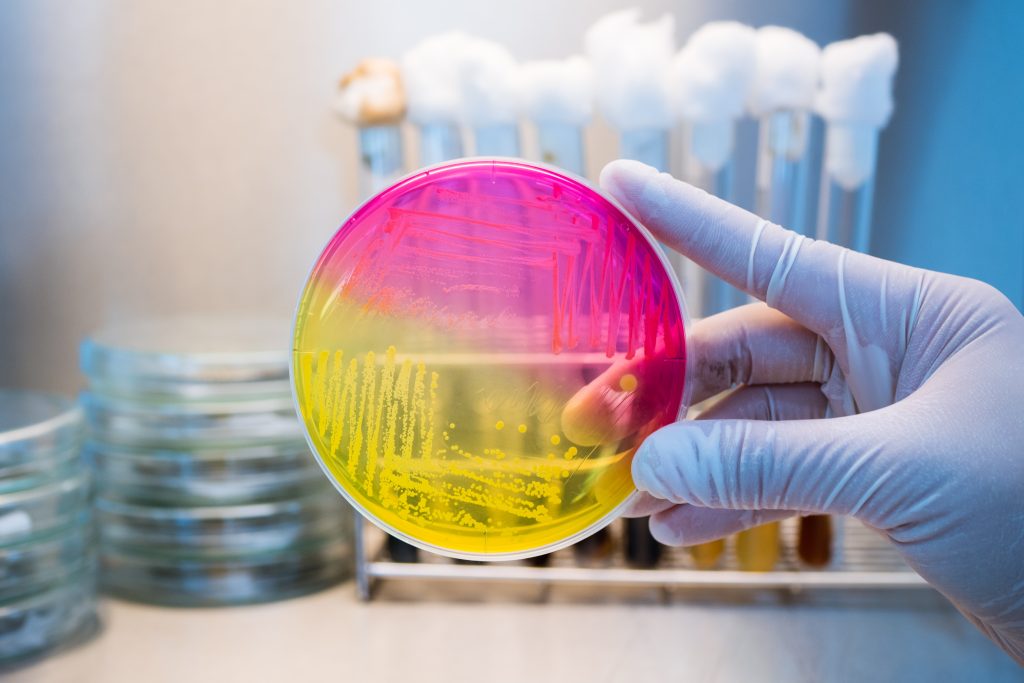

Combinación de Sulbactam/Avibactam
contra Acinetobacter baumannii Multirresistente a los Fármacos
Tratamiento Antimicrobiano Óptimo de la

Neumonía por Acinetobacter baumannii
Sulbactam/Avibactam contra Acinetobacter

baumannii Resistente a Carbapenémicos
Características farmacológicas de Sulbactam

Resistencia Antimicrobiana y Desarrollo
